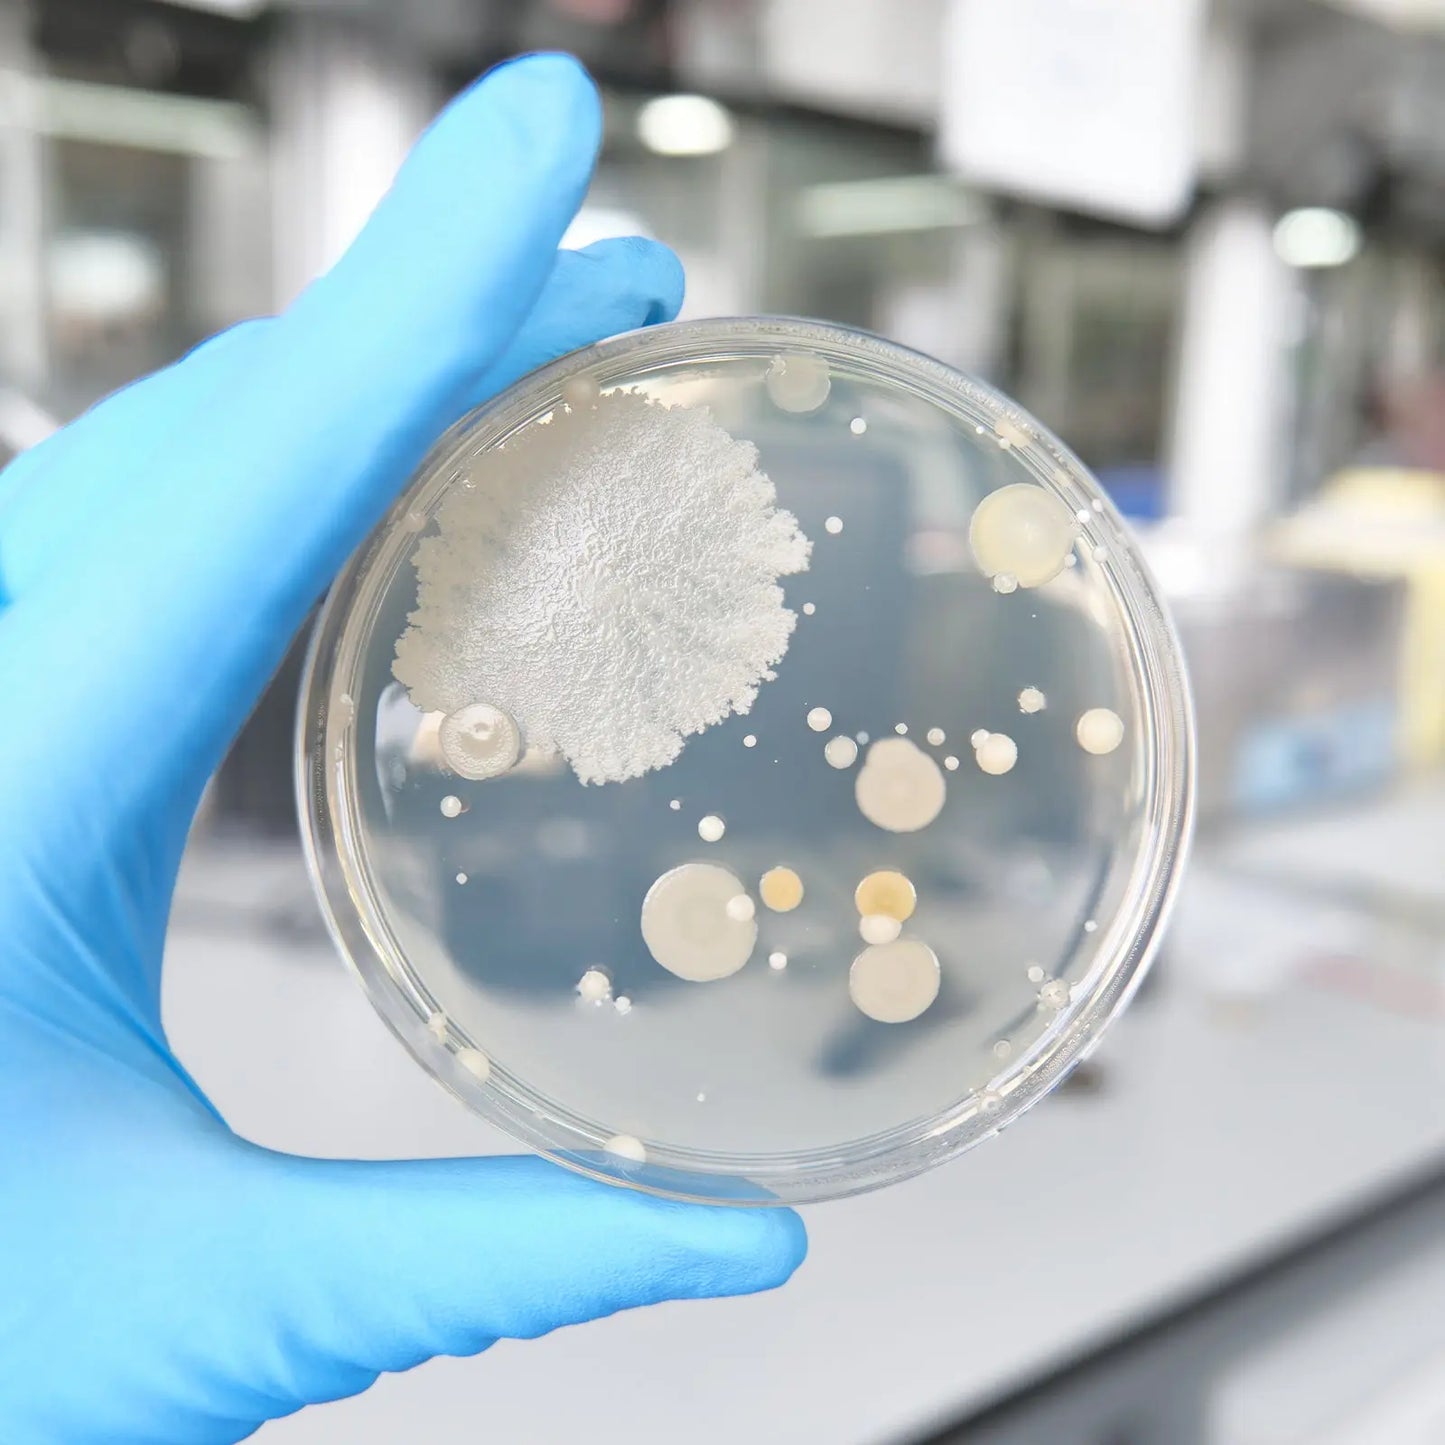
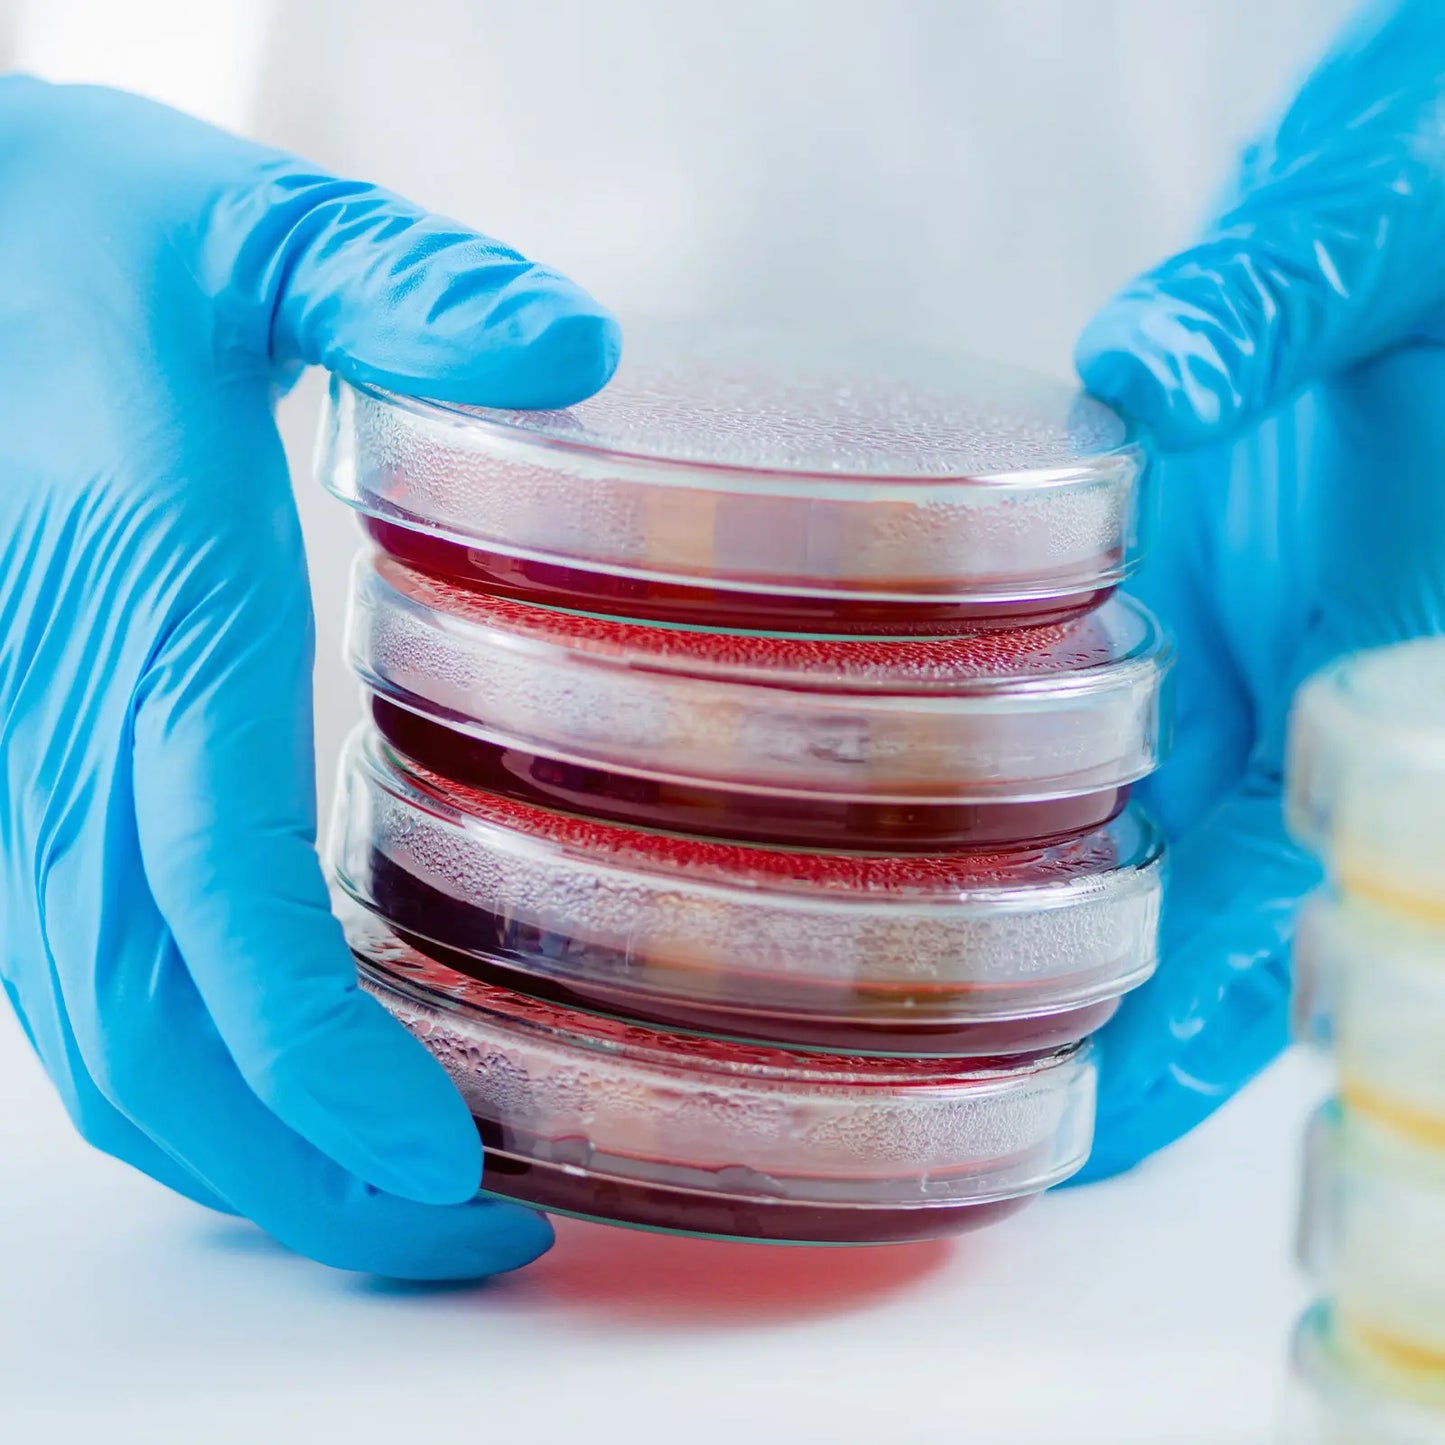

StonyLab
Plastic Petri Dishes, 90x15 mm, 10 Pcs
Plastic Petri Dishes, 90x15 mm, 10 Pcs
SKU:
Couldn't load pickup availability
Processing: 1-3 business days. Shipping: 3-7 business days.
- Versatile Application: primarily used for laboratory analysis, scientific research, seed cultivation, cell culture, and suitable for school science projects
- Key Features: made of disposable polystyrene plastic, smooth surface, high transparency; designed with lids for stackable storage and improved gas exchange
- Size and Packaging: Diameter 3.54 in, Height 0.59 in, packed in bags of 10, outer packaging in cardboard boxes
- Note: plastic petri dishes are not suitable for high-temperature and high-pressure treatment; for heat treatment, please choose glass petri dishes
Contact Us
Contact Us
100% Satisfaction! Please feel free to contact us anytime. All your questions will be answered within timely manner.
Shipping Worldwide
Shipping Worldwide
Yes, StonyLab offers delivery service to customers worldwide! Free standard shipping on labware orders in the US.
2-Year Warranty
2-Year Warranty
Rest easy knowing that all web registered members receive a 1-Year Comprehensive Warranty and an additional 1-Year Limited Warranty on their purchases.
Price Adjustment
Price Adjustment
Buy with confidence! Our 10-day Price Adjustment policy ensures you get the best deal.
Share







Best Seller
-
Lab Continuous Radiation Microwave Chemical Reactor, Rotating Turntable/Magnetic Stirring
Regular price From $1,480.00 USDRegular priceUnit price / per -
Lifting Rotary Single or Dual Jacketed Glass Reactor Systems, 20L
Regular price $9,150.00 USDRegular priceUnit price / per -
Separatory Funnel with 24/29 Joint, PTFE Stopcock, 60-2000 ml
Regular price From $22.99 USDRegular priceUnit price / per -
Digital Magnetic Stirring Heating Mantle with Temperature Probe, 250-1000 ml, RT-300°C, 20-1200 RPM
Regular price From $146.99 USDRegular priceUnit price / per -
Low Temperature Cooling Circulator Pump, 3-9L, -40-100°C, 12-28L/min Circulation Flow Rate
Regular price From $1,899.00 USDRegular priceUnit price / per

BUY MORE, SAVE MORE
Save more when you buy in bulk! Discounts apply to the SAME PRODUCT AND VARIANT of glassware and lab accessories only.
- Buy 10+: 5% off
- Buy 20+ : 8% off
- Buy 30+ : 10% off
- Buy 50+ : 12% off
- Buy 100+ : 15% off
- Buy 200+ : 20% off
Please feel free to contact us 24/7. We are always here to assist you.
- Choosing a selection results in a full page refresh.
- Opens in a new window.